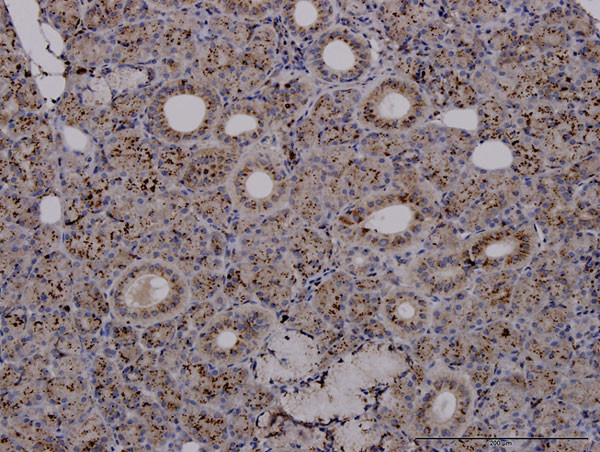
TPP1 Antibody in Immunohistochemistry (Paraffin) (IHC (P))

Search
Abnova
TPP1 Monoclonal Antibody (3B1)
{{$productOrderCtrl.translations['antibody.pdp.commerceCard.promotion.promotions']}}
{{$productOrderCtrl.translations['antibody.pdp.commerceCard.promotion.viewpromo']}}
{{$productOrderCtrl.translations['antibody.pdp.commerceCard.promotion.promocode']}}: {{promo.promoCode}} {{promo.promoTitle}} {{promo.promoDescription}}. {{$productOrderCtrl.translations['antibody.pdp.commerceCard.promotion.learnmore']}}
产品信息
H00001200-M01J
宿主/亚型
分类
类型
克隆号
抗原
偶联物
形式
浓度
规格
保存条件
运输条件
产品详细信息
Sequence of this protein is as follows: GLHLGVTPSV IRKRYNLTSQ DVGSGTSNNS QACAQFLEQY FHDSDLAQFM RLFGGNFAHQ ASVARVVGQQ GRGRAGIEAS LDVQYLMSAG ANISTWVYSS PGRHEGQEPF
Cell culture grade monoclonal antibodies are obtained by purifying "hybridoma culture medium" which completely eliminates any contamination of mice. They have high affinity, high purity, and no contamination.
靶标信息
This gene encodes a member of the sedolisin family of serine proteases. The protease functions in the lysosome to cleave N-terminal tripeptides from substrates, and has weaker endopeptidase activity. It is synthesized as a catalytically-inactive enzyme which is activated and auto-proteolyzed upon acidification. Mutations in this gene result in late-infantile neuronal ceroid lipofuscinosis, which is associated with the failure to degrade specific neuropeptides and a subunit of ATP synthase in the lysosome.
仅用于科研。不用于诊断过程。未经明确授权不得转售。